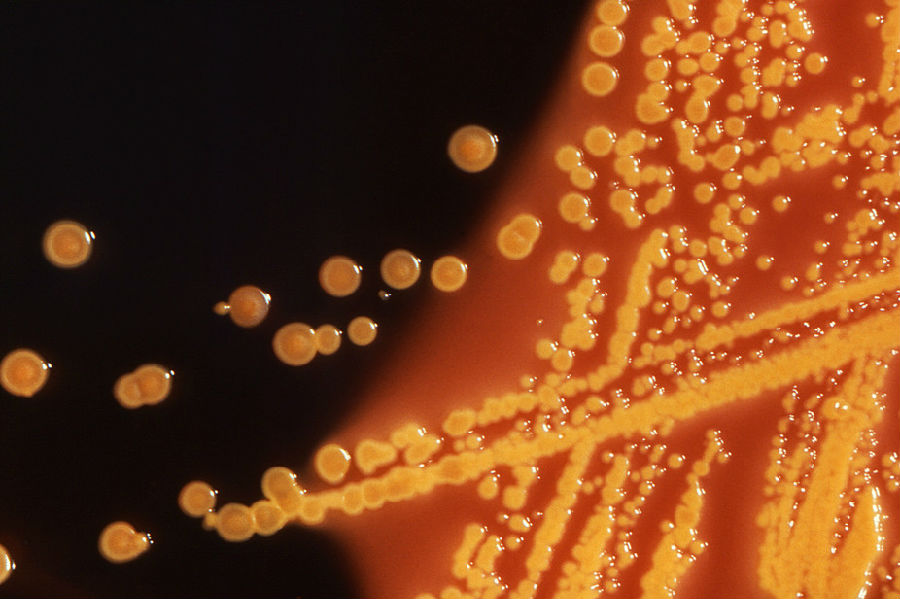

导语:抗生素20世纪人类最伟大的发现之一,一个世纪以来,抗生素被广泛应用于各种细菌感染的治疗。但是由于大量的滥用和误用,如今抗生素抗性已经成为医疗界最为严重的难题之一。本文将主要讲述抗生素抗性的来源以及我们未来的应对策略。
关键词:抗生素;超级细菌;抗生素抗性
沃尔特里德国家军事医疗中心的研究人员在5月26日报道了一种新型超级细菌。这种细菌含有黏菌素(编者注:粘菌素通常被称为人类抵抗病菌的最后一道防线)的抗性基因。这则消息使得卫生官员和科学家们感到深深地担忧,因为这是MCR-1抗性基因首次在美国被发现并确认。
研究人员在一名宾夕法尼亚女性的尿液中的大肠杆菌里发现了这种基因。这名女性在四月下旬接受了尿路感染的治疗,幸运的是,在这个病例中她最终被抗生素治愈了。但是让官方感到担忧的是MCR-1的可移动性,这使得这种基因可能会被传递给其他细菌。
这种担忧换言之就是抗性基因可能与已对其他抗生素具有抗性的细菌相结合,形成一种能够抵抗所有抗生素的超级细菌。
抗生素话题一直以来都不是一个新话题,与此同时这也不是一个能被马上解决的问题。根据疾病控制与预防中心的统计,每年在美国有两百万人感染抗性细菌,其中有23000人因此而死亡。
我们知道滥用和误用抗生素都是抗性产生的主要原因。那么是什么造成了这些过度使用呢?寻找和开发新型抗生素是十分重要的,但是我们是否有其他方法来控制或阻止感染的传播或杀死病原菌呢?
科学家们正在寻找这些答案。以下是一些来自The Conversation US的讨论。
为什么抗生素会被滥用?
抗生素能够显著控制细菌感染,但是对于类似流感的病毒性感染却无能为力。而许多患者却坚持要求使用抗生素,即使对于他们所患的疾病毫无效果。
乔治华盛顿大学对巴尔的摩一个急诊室的调查指出约有四分之三的被调查患者希望能够使用抗生素仅仅是出于“以防万一”或“这是无害的”的想法。
医生之间对于患者的争夺也使得医生更倾向于开具抗生素处方药,某些医务人员在这其中起到了重大的作用。
例如皮肤科医生仅占所有内科医生中的1%,却开具了5%的抗生素处方。与此同时他们的病人使用抗生素的时间也比国家推荐的指导值更长更高,剂量也高于比所需的值。正如皮肤科专家亚当·弗里德曼所解释的:
通常医生会使用比所需剂量更高的抗生素来治疗痤疮。虽然抗生素能够杀死痤疮细菌,但这是出于它们的抗炎效果而非抗菌效果。这也使得痤疮细菌对一些抗生素产生了广泛抗性,同时过度使用也使得一些例如金黄色葡萄球菌和链球菌的致病菌产生了抗性。
我们对于抗性细菌了解多少?
传统的理论认为抗性细菌的生存能力比一般细菌更差。但是最近一个国际研究组织指出抗性细菌的生存能力和致病性都更强。这一理论并不适用于所有细
到处都有细菌,它们不仅遍布你的皮肤和身体,同时也覆盖了每一个你能接触到的角落。俄亥俄大学的室内环境微生物研究学者艾丽卡·哈特曼提出是否例如肥皂、清洁用具等抗菌物质可能会促进抗性的传播。她目前正在进行的研究包括收集公共场所下水槽、马桶后以及沿着墙壁和隔间上的尘土样品。
事实上,大多数的细菌喜欢集结在生物膜系统中。也正是这些生物膜系统造成了大部分的在医院见到的感染案例。目前科学家们还未完全理解其中的机理,生物膜的生存方式使得细菌对于消毒剂和所有的抗生素的敏感程度下降。
宾汉姆顿大学的卡琳·萨奥尔描述了她和其他研究人员正在致力于探究细菌在生物膜系统中的交流和协调方式,从而找到对抗该系统的方法。
但是这其中也有好消息,对吧?
随着对于抗生素武器库的抗性不断增长,科学家们正在寻找新的回击方式。
举个例子,我们是否能够找到一种方法能够特异性去除其中的致病菌,同时又能够保留其中的有益菌或无害菌呢?并且我们是否能够确定这些坏细菌不太容易对特异性消除产生抗性?
CRISPR基因编辑技术通过除去靶向基因,能够帮助我们使用细菌自身免疫系统来使其凋亡。
另一个可供参考的选项是利用银的天然抗菌性。
与此同时科罗拉多大学波尔得分校的研究人员正在尝试使用纳米材料(10-9米)靶向去除耐药细菌,同时免除伤害体内的健康组织。
让我们看看抗生素出现之前的世界
我们需要新的抗生素,但是与细菌抗药性斗争还需要其他的治疗方法。
正如MCR-1发现后疾病控制与预防中心主任汤姆·弗里登在5月26日一次新闻发布会上所说的:
我们能够制造新药,但是如果缺乏更好的疾病管理和鉴别工作,我们将会失去这些神奇的药。对于一些患者而言,我们已经没有有效的药品了。如果我们再不拿出行动,这就可能是抗生素的末路了。那么后抗生素的时代是什么样子的呢?换一种方式而言,当抗生素存在之前,我们又是如何治疗细菌感染的呢?
正如来自德克萨斯A&M健康科学中心的克里斯蒂·哥伦布所说的那样,在那个时代,我们通常会采用放血、水银和植物疗法,这些疗法取得了不同程度的成功。她警告说:从古至今我们经历了许多治疗感染的方法,但是从来没有一种疗法能够像抗生素治疗法一样安全可靠。不幸的是,随着不断增长的抗性和新型药物的短缺,我们可能又会回到那个没有抗生素治疗的年代。
(翻译:岑天宇 审校:张玲)
作者信息:Jessie Schanzle是《Health and Medicine》的文字编辑。
原文链接【科学美国人博客】:
https://theconversation.com/perspectives-on-antibiotic-resistance-how-we-got-here-where-were-headed-60140



















留言